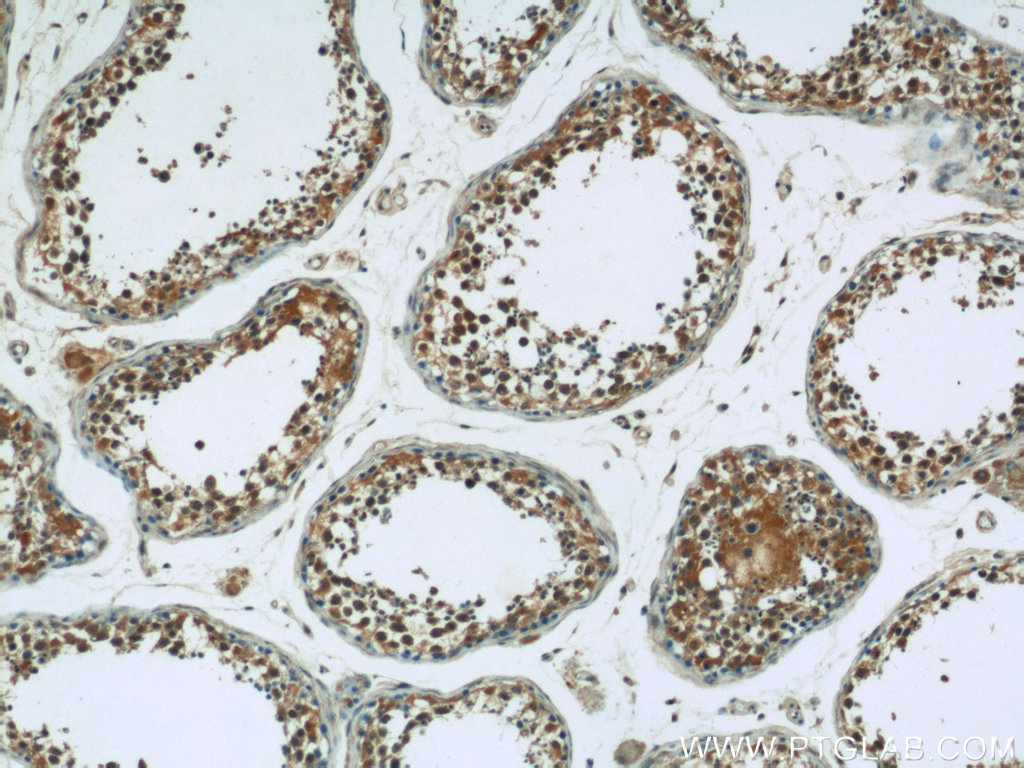

AMPK gamma 1抗体
产品名称: AMPK gamma 1抗体
英文名称: AMPK gamma 1Antibody
产品编号: XY10290-1
产品价格: null
产品产地: 中国/美国
品牌商标: XYbscience
更新时间: 2023-08-17T09:55:27
使用范围: WB,ELISA,IHC-P,IHC-F,IF
- 联系人 : 徐经理
- 地址 : 上海市闵行莘庄工业区春东路508号A1-2F
- 邮编 : 200612
- 所在区域 : 上海
- 电话 : 152****8802 点击查看
- 传真 : 点击查看
- 邮箱 : shxysw02@163.com
- 二维码 : 点击查看
AMPK GAMMA 1抗体
IP = Immunoprecipitation
XY822Hu22 角蛋白17(KRT17)单克隆抗体 Monoclonal Antibody to Keratin 17 (KRT17) Homo sapiens (Hukl)
XY823Hu22 补体成分9(C9)单克隆抗体 Monoclonal Antibody to Complement Component 9 (C9) Homo sapiens (Hukl)
XY824Hu22 核因子κB(NFκB)单克隆抗体 Monoclonal Antibody to Nuclear Factor Kappa B (NFkB) Homo sapiens (Hukl)
XY826Hu22 V-Rel网状内皮增生病毒癌基因同源物B(RELB)单克隆抗体 Monoclonal Antibody to V-Rel Reticuloendotheliosis Viral Oncogene Homolog B (RELB) Homo sapiens (Hukl)
XY827Hu22 轴突生长诱向因子1(Ntn1)单克隆抗体 Monoclonal Antibody to Netrin 1 (Ntn1) Homo sapiens (Hukl)
XY828Hu22 载脂蛋白C4(APOC4)单克隆抗体 Monoclonal Antibody to Apolipoprotein C4 (APOC4) Homo sapiens (Hukl)
XY829Hu22 解整合素金属蛋白酶9(ADAM9)单克隆抗体 Monoclonal Antibody to A Disintegrin And Metalloprotease 9 (ADAM9) Homo sapiens (Hukl)
XY830Hu22 组织转谷氨酰胺酶(TGM2)单克隆抗体 Monoclonal Antibody to Transglutaminase 2, Tissue (TGM2) Homo sapiens (Hukl)
XY831Hu22 音猬因子(SHH)单克隆抗体 Monoclonal Antibody to Hedgehog Homolog, Sonic (SHH) Homo sapiens (Hukl)
XY833Hu22 补体因子D(CFD)单克隆抗体 Monoclonal Antibody to Complement Factor D (CFD) Homo sapiens (Hukl)
XY834Hu22 凝血因子Ⅺ(F11)单克隆抗体 Monoclonal Antibody to Coagulation Factor XI (F11) Homo sapiens (Hukl)
XY835Hu22 轴突生长诱向因子4(Ntn4)单克隆抗体 Monoclonal Antibody to Netrin 4 (Ntn4) Homo sapiens (Hukl)
XY837Hu22 白介素2受体α(IL2Rα)单克隆抗体 Monoclonal Antibody to Interleukin 2 Receptor Alpha (IL2Ra) Homo sapiens (Hukl)
XY839Hu22 纽蛋白(VCL)单克隆抗体 Monoclonal Antibody to Vinculin (VCL) Homo sapiens (Hukl)
XY840Hu22 小乳腺表皮粘蛋白(SBEM)单克隆抗体 Monoclonal Antibody to Skll Breast Epithelial Mucin (SBEM) Homo sapiens (Hukl)
XY844Hu22 桩蛋白(Pax)单克隆抗体 Monoclonal Antibody to Paxillin (Pax) Homo sapiens (Hukl)
XY845Hu22 CD83分子(CD83)单克隆抗体 Monoclonal Antibody to Cluster Of Differentiation 83 (CD83) Homo sapiens (Hukl)
XY848Hu22 核因子κB抑制因子α(IκBα)单克隆抗体 Monoclonal Antibody to Inhibitory Subunit Of NF Kappa B Alpha (IkBa) Homo sapiens (Hukl)
XY850Hu22 β-1,4-半乳糖转移酶1(β4GALT1)单克隆抗体 Monoclonal Antibody to Beta-1,4-Galactosyltransferase 1 (b4GALT1) Homo sapiens (Hukl)
XY852Hu22 含Rho关联卷曲螺旋蛋白激酶2(Rock2)单克隆抗体 Monoclonal Antibody to Rho Associated Coiled Coil Containing Protein Kinase 2 (Rock2) Homo sapiens (Hukl)
XY853Hu22 基质金属蛋白酶19(MMP19)单克隆抗体 Monoclonal Antibody to klrix Metalloproteinase 19 (MMP19) Homo sapiens (Hukl)
XY854Hu22 钙腔蛋白(CALU)单克隆抗体 Monoclonal Antibody to Calumenin (CALU) Homo sapiens (Hukl)
XY856Hu22 Ⅰ类主要组织相容性复合体G(MHCG)单克隆抗体 Monoclonal Antibody to klor Histocompatibility Complex Class I G (MHCG) Homo sapiens (Hukl)
XY859Hu22 凝集素样氧化低密度脂蛋白受体1(LOX1)单克隆抗体 Monoclonal Antibody to Lectin Like Oxidized Low Density Lipoprotein Receptor 1 (LOX1) Homo sapiens (Hukl)
XY860Hu22 胎球蛋白B(FETUB)单克隆抗体 Monoclonal Antibody to Fetuin B (FETUB) Homo sapiens (Hukl)
XY864Hu22 乳酸脱氢酶(LDH)单克隆抗体 Monoclonal Antibody to Lactate Dehydrogenase (LDH) Homo sapiens (Hukl)
XY866Hu22 神经调节素1(NRG1)单克隆抗体 Monoclonal Antibody to Neuregulin 1 (NRG1) Homo sapiens (Hukl)
XY867Hu22 表皮生长因子受体2(EGFR2)单克隆抗体 Monoclonal Antibody to Epiderkl Growth Factor Receptor 2 (EGFR2) Homo sapiens (Hukl)